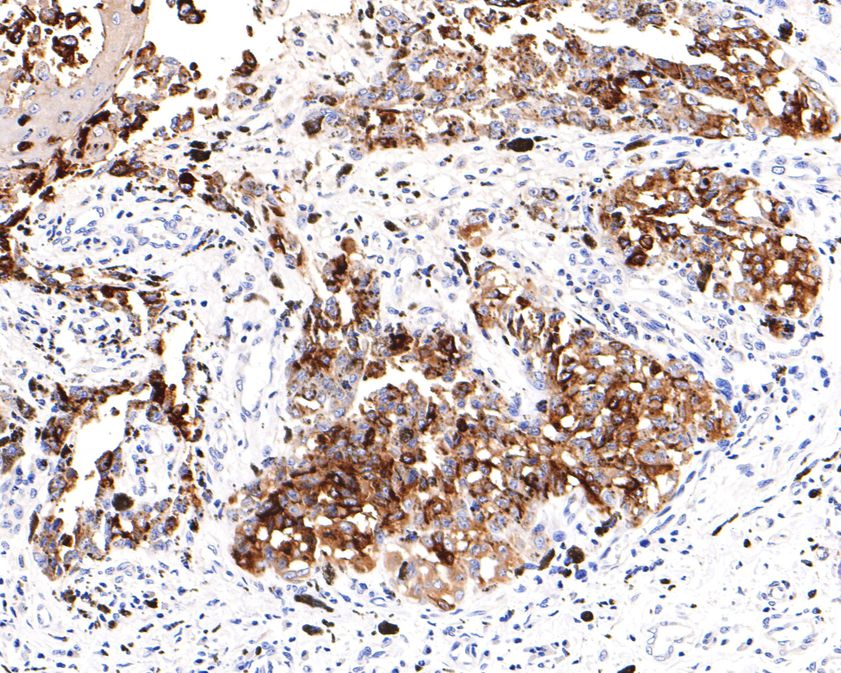
TYRP1 Recombinant Rabbit mAb(b

相关产品推荐更多 >

CXorf21 Rabbit pAb, PerCP conjugated(bs-9552R-PerCP)-100ul
¥2980
IGF2R/M6PR Rabbit pAb, RBITC conjugated(bs-6670R-RBITC)-100ul
¥2980
phospho-FANCD2 (Ser1404) Rabbit pAb, Cy5 conjugated(bs-13141R-Cy5)-100ul
¥2980
SOX9 Rabbit pAb, HRP conjugated(bs-10725R-HRP)-100ul
¥2980
NCX3 Rabbit pAb(bs-2057R)-50ul/100ul/200ul
¥1180
万千商家帮你免费找货
0 人在求购买到急需产品
- 详细信息
- 技术资料
- 应用范围:
产品信息以Bioss网站为准
- 规格:
50ul/100ul
| 规格: | 50ul | 产品价格: | ¥1400.0 |
|---|---|---|---|
| 规格: | 100ul | 产品价格: | ¥2500.0 |
| 产品编号 | bsm-54216R |
| 英文名称 | TYRP1 Recombinant Rabbit mAb |
| 中文名称 | 酪氨酸酶相关蛋白1重组兔单抗 |
| 英文别名 | TRP; CAS2; CATB; GP75; OCA3; TRP1; TYRP; TRP-1; b-PROTEIN; tyrosinase related protein 1; TYRRP; 5, 6-dihydroxyindole-2-carboxylic acid oxidase; EC:1.14.18; Catalase B; Glycoprotein 75; Melanoma antigen gp75; Tyrosinase-related protein 1; TYRP1_HUMAN; |
| 产品应用 | WB=1:500-2000, IHC-P=1:100-200, IHC-F=1:100-200, IF=1:100-200, IP=1:20-50 Not yet tested in other applications. |
| 交叉反应 | Human |
| 抗体来源 | Rabbit |
| 免疫原 | Recombinant human TRP1 protein |
| 亚型 | IgG |
| 性状 | Liquid |
| 纯化方法 | affinity purified by Protein A |
| 克隆类型 | Recombinant |
| 理论分子量 | 58 kDa |
| 浓度 | 1mg/ml |
| 储存液 | 0.01M TBS (pH7.4) with 1% BSA, 0.02% Proclin300 and 50% Glycerol. |
| 亚细胞定位 | Melanosome membrane; Single-pass type I membrane protein (By similarity). Note=Located to mature stage III and IV melanosomes and apposed endosomal tubular membranes. Transported to pigmented melanosomes by the BLOC-1 complex (By similarity). |
| 组织特异性 | Pigment cells. |
| 相似性 | Belongs to the tyrosinase family. |
| 功能 | Oxidation of 5,6-dihydroxyindole-2-carboxylic acid (DHICA) into indole-5,6-quinone-2-carboxylic acid. May regulate or influence the type of melanin synthesized. |
| 保存条件 | Shipped at 4℃. Store at -20℃ for one year. Avoid repeated freeze/thaw cycles. |
| 注意事项 | This product as supplied is intended for research use only, not for use in human, therapeutic or diagnostic applications. |
| 背景资料 | TRP1 is a melanosomal enzyme that belongs to the tyrosinase family and plays an important role in the melanin biosynthetic pathway. Defects in this gene are the cause of rufous oculocutaneous albinism and oculocutaneous albinism type III. |
| 应用 | 推荐稀释比例 |
| {WB} | {1:500-2000} |
| {IHC-P} | {1:100-200} |
| {IHC-F} | {1:100-200} |
| {IF} | {1:100-200} |
| {IP} | {1:20-50} |

ICC staining of TRP1 in HUVEC cells (green). Formalin fixed cells were permeabilized with 0.1% Triton X-100 in TBS for 10 minutes at room temperature and blocked with 10% negative goat serum for 15 minutes at room temperature. Cells were probed with the primary antibody (bsm-54216R, 1/50) for 1 hour at room temperature, washed with PBS. Alexa Fluor®488 conjugate-Goat anti-Rabbit IgG was used as the secondary antibody at 1/1,000 dilution. The nuclear counter stain is DAPI (blue).

Immunohistochemical analysis of paraffin-embedded human skin tissue using anti-TRP1 antibody. The section was pre-treated using heat mediated antigen retrieval with Tris-EDTA buffer (pH 9.0) for 20 minutes.The tissues were blocked in 1% BSA for 30 minutes at room temperature, washed with ddH2O and PBS, and then probed with the primary antibody (bsm-54216R, 1/100) for 30 minutes at room temperature. The detection was performed using an HRP conjugated compact polymer system. DAB was used as the chromogen. Tissues were counterstained with hematoxylin and mounted with DPX.
Immunohistochemical analysis of paraffin-embedded human malignant melanoma tissue using anti-TRP1 antibody. The section was pre-treated using heat mediated antigen retrieval with Tris-EDTA buffer (pH 9.0) for 20 minutes.The tissues were blocked in 1% BSA for 30 minutes at room temperature, washed with ddH2O and PBS, and then probed with the primary antibody (bsm-54216R, 1/400) for 30 minutes at room temperature. The detection was performed using an HRP conjugated compact polymer system. DAB was used as the chromogen. Tissues were counterstained with hematoxylin and mounted with DPX.
风险提示:丁香通仅作为第三方平台,为商家信息发布提供平台空间。用户咨询产品时请注意保护个人信息及财产安全,合理判断,谨慎选购商品,商家和用户对交易行为负责。对于医疗器械类产品,请先查证核实企业经营资质和医疗器械产品注册证情况。
 技术资料
技术资料暂无技术资料 索取技术资料
TYRP1 Recombinant Rabbit mAb(bsm-54216R)-50ul/100ul
¥1400 - 2500





